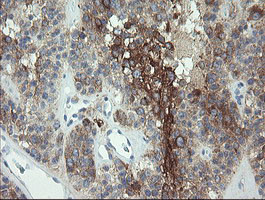
EIF5A2 Antibody in Immunohistochemistry (Paraffin) (IHC (P))

Search
OriGene
EIF5A2 Monoclonal Antibody (OTI6F7), TrueMAB™
{{$productOrderCtrl.translations['antibody.pdp.commerceCard.promotion.promotions']}}
{{$productOrderCtrl.translations['antibody.pdp.commerceCard.promotion.viewpromo']}}
{{$productOrderCtrl.translations['antibody.pdp.commerceCard.promotion.promocode']}}: {{promo.promoCode}} {{promo.promoTitle}} {{promo.promoDescription}}. {{$productOrderCtrl.translations['antibody.pdp.commerceCard.promotion.learnmore']}}
产品信息
CF505147
宿主/亚型
分类
类型
克隆号
抗原
偶联物
形式
浓度
规格
保存条件
运输条件
产品详细信息
For reconstitution, we recommend adding 100 µL distilled water to a final antibody concentration of about 1 mg/mL. To use this carrier-free antibody for conjugation experiments, we strongly recommend performing another round of desalting. (Zeba Spin Desalting Columns, 7KMWCO, 0.5 mL, Product # 89882)
靶标信息
mRNA-binding protein involved in translation elongation. Has an important function at the level of mRNA turnover, probably acting downstream of decapping. Involved in actin dynamics and cell cycle progression, mRNA decay and probably in a pathway involved in stress response and maintenance of cell wall integrity. Functions as a regulator of apoptosis. Mediates effects of polyamines on neuronal process extension and survival. May play an important role in brain development and function, and in skeletal muscle stem cell differentiation.
仅用于科研。不用于诊断过程。未经明确授权不得转售。